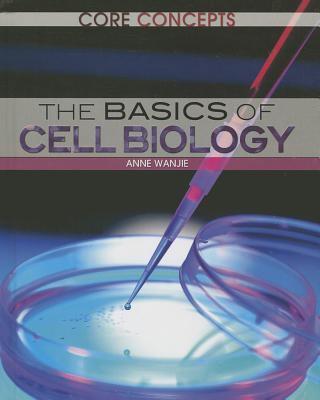
The Basics of Cell Biology 1477705481 Book Cover

This text provides readers with a comprehensive study of the mechanics of cell biology that aligns with Core Curriculum requirements in science. Topics covered range from the different types of cells-- plant and animal, eukaryote and prokaryote, and stem cells--to the components...